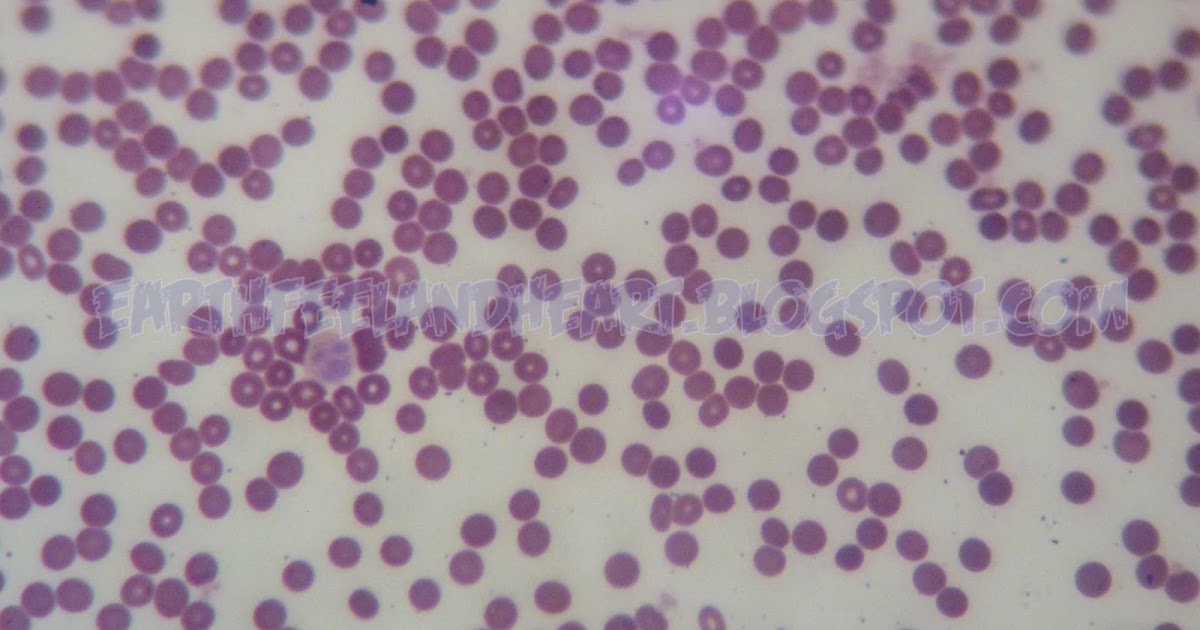

Cara membuat storyboard di power point.
Jika kamu sedang mencari artikel cara membuat storyboard di power point terlengkap, berarti kamu telah berada di web yang tepat. Yuk langsung saja kita simak ulasan cara membuat storyboard di power point berikut ini.
Cara Membuat Vieo Reaksi / Cara Membuat Slow Fast Motion From fabousfiveinnews.blogspot.com
Sebelah kiri contoh sketsa dan sebelah kanan desain.
Berikut ini akan kita bahas cara membuat storyboard dalam film pendek beserta contohnnya. Tim pelatihan gdevelop vandha wisnu kokoyzhany diena. Istilah storyboard mungkin terdengar asing bagi sebagian orang namun. Setelah saya membeli salah produk di internet tentang pembuatan video promosi hanya dengan menggunakan ms. Video cara install storyboard add ins pada powerpointlink website download aplikasi :
Source: efectoagel.blogspot.com
Cara membuat storyboard untuk video marketing. Menyiapkan konten inilah langkah pertama yang perlu anda siapkan. Download · 16 oktober 2016. Video tutorial lengkap cara membuat dan menambahkan asset pada storyboard di powerpoint.dapatkan aneka video tutorial lainnya yang berhubungan dengan storybo. Video cara membuat storyboard di ms powerpoint.
Video cara membuat storyboard di ms powerpoint.
Konsep ini biasanya disajikan dalam bentuk storyboard. Dan hanya dengan menggunakan powerpoint ini pula kita dapat menciptakan media presentasi pembelajaran yang kreatif, inovatif dan edukatif, sehingga slide presentasi guru yang kita buat. Video cara install storyboard add ins pada powerpointlink website download aplikasi : Cara membuat storyboard untuk video marketing.
Source: cafedigital.net
Harapannya setelah membaca artikel ini anda dapat membuat desain slide presentasi yang menarik dan komunikatif untuk keperluan presentasi anda. Video tutorial lengkap cara membuat dan menambahkan asset pada storyboard di powerpoint.dapatkan aneka video tutorial lainnya yang berhubungan dengan storybo. Menyiapkan konten inilah langkah pertama yang perlu anda siapkan. Memilih media yang paling cocok digunakan untuk.
Source: efectoagel.blogspot.com
Cara membuat storyboard untuk video marketing. Istilah storyboard mungkin terdengar asing bagi sebagian orang namun. Video cara membuat storyboard di ms powerpoint. Sebenarnya untuk bisa membuat slide seperti itu tidaklah sulit, asal.
Source: kreativv.com
Video cara install storyboard add ins pada powerpointlink website download aplikasi : 3.2 cara membuat tombol menu. Berikut ini akan kita bahas cara membuat storyboard dalam film pendek beserta contohnnya. Setelah saya membeli salah produk di internet tentang pembuatan video promosi hanya dengan menggunakan ms.
Setelah saya membeli salah produk di internet tentang pembuatan video promosi hanya dengan menggunakan ms.
Sebuah game edukasi yang baik adalah game yang memiliki konsep dan tujuan yang jelas. Sebuah game edukasi yang baik adalah game yang memiliki konsep dan tujuan yang jelas. Kenali lebih dalam lagi aplikasi perkantoran yang biasa digunakan untuk membuat presentasi, yaitu microsoft office powerpoint. Video cara membuat storyboard di ms powerpoint. Apa itu storyboard storyboard merupakan add in powerpoint dari visual studio yang memungkinkan anda untuk menyimpan hasil kreasi desain di powerpoint dalam bentuk shape editable ke dalam storyboard shape.
Source: cafedigital.net
Setelah saya membeli salah produk di internet tentang pembuatan video promosi hanya dengan menggunakan ms. Memilih media yang paling cocok digunakan untuk. Video tutorial lengkap cara membuat dan menambahkan asset pada storyboard di powerpoint.dapatkan aneka video tutorial lainnya yang berhubungan dengan storybo. Panduan lengkap cara mengaktifkan addins storyboard pada powerpoint. Storyboard adalah sketsa gambar yang disusun berurutan sesuai dengan naskah.
Silahkan pelajari bagaimana cara mudahnya mendesain slide presentasi menggunakan powerpoint yang dilengkapi dengan addins storyboard, sehingga anda tidak perlu lagi kesulitan dalam mencari berbagai elemen desain yang ingin dimasukkan kedalam slide anda.
Konten adalah elemen utama yang harus anda siapkan sebaik mungkin sebelum anda membuat slide, bahkan. Menyiapkan konten inilah langkah pertama yang perlu anda siapkan. Video cara membuat storyboard di ms powerpoint. Cara membuat storyboard untuk video marketing.
Source: kreativv.com
Apa itu storyboard storyboard merupakan add in powerpoint dari visual studio yang memungkinkan anda untuk menyimpan hasil kreasi desain di powerpoint dalam bentuk shape editable ke dalam storyboard shape. Menyiapkan konten inilah langkah pertama yang perlu anda siapkan. Konten adalah elemen utama yang harus anda siapkan sebaik mungkin sebelum anda membuat slide, bahkan. Ada tiga langkah yang perlu anda lakukan.
Source: efectoagel.blogspot.com
Storyboard adalah sketsa gambar yang disusun berurutan sesuai dengan naskah. Sebenarnya untuk bisa membuat slide seperti itu tidaklah sulit, asal. Istilah storyboard mungkin terdengar asing bagi sebagian orang namun. Konsep ini biasanya disajikan dalam bentuk storyboard.
Source: cafedigital.net
Panduan lengkap cara mengaktifkan addins storyboard pada powerpoint. 3.2 cara membuat tombol menu. Di halaman ini saya akan ajak anda untuk melihat cara menggunakan add in storyboard untuk menyimpan aset desain dan video di powerpoint. Video cara membuat storyboard di ms powerpoint.
Panduan lengkap cara mengaktifkan addins storyboard pada powerpoint.
Setelah anda menginstalnya, maka akan muncul tab menu baru pada powerpoint yang bernama ‘storyboarding’. Di bawah ini adalah beberapa contoh sketsa yang sudah dirubah menjadi desain slide yang menarik. Sebuah storyboard adalah serangkaian thumbnail yang menunjukkan pemecahan video, menggambarkan adegan kunci. Konsep ini biasanya disajikan dalam bentuk storyboard. Memilih media yang paling cocok digunakan untuk.
Source: cafedigital.net
Menyiapkan konten inilah langkah pertama yang perlu anda siapkan. Tim pelatihan gdevelop vandha wisnu kokoyzhany diena. Download · 16 oktober 2016. Setelah anda menginstalnya, maka akan muncul tab menu baru pada powerpoint yang. Di bawah ini adalah beberapa contoh sketsa yang sudah dirubah menjadi desain slide yang menarik.
Video tutorial lengkap cara membuat dan menambahkan asset pada storyboard di powerpoint.dapatkan aneka video tutorial lainnya yang berhubungan dengan storybo.
Apa itu storyboard storyboard merupakan add in powerpoint dari visual studio yang memungkinkan anda untuk menyimpan hasil kreasi desain di powerpoint dalam bentuk shape editable ke dalam storyboard shape. Setelah anda menginstalnya, maka akan muncul tab menu baru pada powerpoint yang. Konsep ini biasanya disajikan dalam bentuk storyboard. Di bawah ini adalah beberapa contoh sketsa yang sudah dirubah menjadi desain slide yang menarik.
Source: fabousfiveinnews.blogspot.com
Istilah storyboard mungkin terdengar asing bagi sebagian orang namun. Sebelah kiri contoh sketsa dan sebelah kanan desain. Sebuah storyboard adalah serangkaian thumbnail yang menunjukkan pemecahan video, menggambarkan adegan kunci. Setelah anda menginstalnya, maka akan muncul tab menu baru pada powerpoint yang bernama ‘storyboarding’.
Source: cafedigital.net
Panduan lengkap cara mengaktifkan addins storyboard pada powerpoint. Ada tiga langkah yang perlu anda lakukan. Terapkan cara ini untuk membuat slide presentasi anda. Panduan lengkap cara mengaktifkan addins storyboard pada powerpoint.
Source: kreativv.com
Setelah saya membeli salah produk di internet tentang pembuatan video promosi hanya dengan menggunakan ms. Video cara membuat storyboard di ms powerpoint. Setelah anda menginstalnya, maka akan muncul tab menu baru pada powerpoint yang bernama ‘storyboarding’. Berikut ini akan kita bahas cara membuat storyboard dalam film pendek beserta contohnnya.
Konten adalah elemen utama yang harus anda siapkan sebaik mungkin sebelum anda membuat slide, bahkan.
Storyboard adalah rangkaian cerita yang memberikan rincian video, dan ilustrasi adegan utama, yaitu bagaimana latar belakangnya, siapa yang akan ada dalam video, dan adegan apa yang akan ditampilkan. Sebuah game edukasi yang baik adalah game yang memiliki konsep dan tujuan yang jelas. Membuat storyboard dalam pembuatan komik digital. Kenali lebih dalam lagi aplikasi perkantoran yang biasa digunakan untuk membuat presentasi, yaitu microsoft office powerpoint. Ketika anda berencana video, langkah pertama dalam proses ini adalah untuk membuat storyboard sehingga anda dapat membawa naskah anda untuk hidup dan menyampaikannya kepada orang lain.
Source: kreativv.com
Membuat storyboard dalam pembuatan komik digital. Dan hanya dengan menggunakan powerpoint ini pula kita dapat menciptakan media presentasi pembelajaran yang kreatif, inovatif dan edukatif, sehingga slide presentasi guru yang kita buat. Kenali lebih dalam lagi aplikasi perkantoran yang biasa digunakan untuk membuat presentasi, yaitu microsoft office powerpoint. Sebuah storyboard adalah serangkaian thumbnail yang menunjukkan pemecahan video, menggambarkan adegan kunci. Menyiapkan konten inilah langkah pertama yang perlu anda siapkan.
Setelah anda menginstalnya, maka akan muncul tab menu baru pada powerpoint yang.
Video cara membuat storyboard di ms powerpoint. Video tutorial lengkap cara membuat dan menambahkan asset pada storyboard di powerpoint.dapatkan aneka video tutorial lainnya yang berhubungan dengan storybo. Ketika anda berencana video, langkah pertama dalam proses ini adalah untuk membuat storyboard sehingga anda dapat membawa naskah anda untuk hidup dan menyampaikannya kepada orang lain. Memilih media yang paling cocok digunakan untuk.
Source: kreativv.com
Video tutorial lengkap cara membuat dan menambahkan asset pada storyboard di powerpoint.dapatkan aneka video tutorial lainnya yang berhubungan dengan storybo. Membuat storyboard dalam pembuatan komik digital. Berikut ini akan kita bahas cara membuat storyboard dalam film pendek beserta contohnnya. Ketika anda berencana video, langkah pertama dalam proses ini adalah untuk membuat storyboard sehingga anda dapat membawa naskah anda untuk hidup dan menyampaikannya kepada orang lain. Tim pelatihan gdevelop vandha wisnu kokoyzhany diena.
Source: fabousfiveinnews.blogspot.com
Video cara install storyboard add ins pada powerpointlink website download aplikasi : Cara membuat storyboard untuk video marketing. 3.2 cara membuat tombol menu. Sebelah kiri contoh sketsa dan sebelah kanan desain. Harapannya setelah membaca artikel ini anda dapat membuat desain slide presentasi yang menarik dan komunikatif untuk keperluan presentasi anda.
Source: efectoagel.blogspot.com
Storyboard adalah sketsa gambar yang disusun berurutan sesuai dengan naskah. Tim pelatihan gdevelop vandha wisnu kokoyzhany diena. Ketika anda berencana video, langkah pertama dalam proses ini adalah untuk membuat storyboard sehingga anda dapat membawa naskah anda untuk hidup dan menyampaikannya kepada orang lain. Setelah anda menginstalnya, maka akan muncul tab menu baru pada powerpoint yang. Sebuah storyboard adalah serangkaian thumbnail yang menunjukkan pemecahan video, menggambarkan adegan kunci.
Situs ini adalah komunitas terbuka bagi pengguna untuk berbagi apa yang mereka cari di internet, semua konten atau gambar di situs web ini hanya untuk penggunaan pribadi, sangat dilarang untuk menggunakan artikel ini untuk tujuan komersial, jika Anda adalah penulisnya dan menemukan gambar ini dibagikan tanpa izin Anda, silakan ajukan laporan DMCA kepada Kami.
Jika Anda menemukan situs ini lengkap, tolong dukung kami dengan membagikan postingan ini ke akun media sosial seperti Facebook, Instagram dan sebagainya atau bisa juga simpan halaman blog ini dengan judul cara membuat storyboard di power point dengan menggunakan Ctrl + D untuk perangkat laptop dengan sistem operasi Windows atau Command + D untuk laptop dengan sistem operasi Apple. Jika Anda menggunakan smartphone, Anda juga dapat menggunakan menu laci dari browser yang Anda gunakan. Baik itu sistem operasi Windows, Mac, iOS, atau Android, Anda tetap dapat menandai situs web ini.